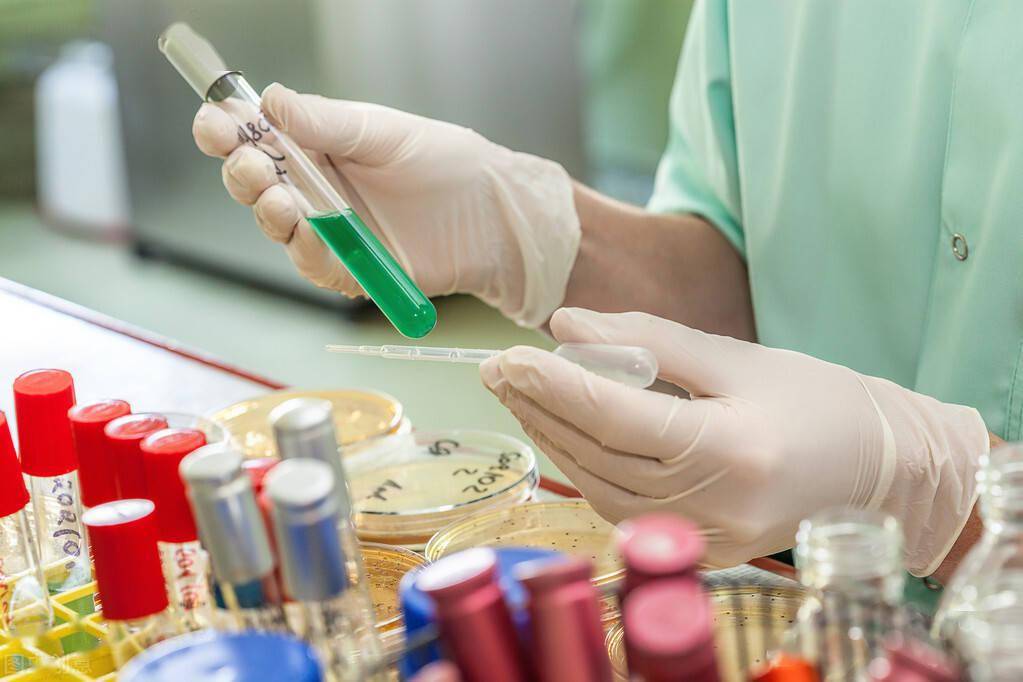
吃什么药能预防老年痴呆症 120d29077845460b944c5e9d84cd4d13.jpeg

吃什么药能预防老年痴呆症_吃什么药能预防老年痴呆症呢
*** 次数:1999998 已用完,请联系开发者***

老年痴呆预防:从日常饮食中的蔬果摄入说起长期不食用番茄,则可能让大脑受损更严重。 番茄红素的抗氧化功能有助于老年人维持神经系统健康,减缓衰老。对于中老年人来说,适量食用番茄能预防记忆力衰退,降低老年痴呆风险。 香蕉 香蕉是日常常见水果,但它与老年痴呆的关系却很少被提及。其实,香蕉富含钾元素,能调节体内电...

年轻人提前吃含类黄酮食物,能预防老年痴呆?嘿,你有没有发现,现在的年轻人一边熬夜蹦迪,一边保温杯里泡枸杞。在养生这条路上可是越走越远啦,尤其是对老年痴呆这种病,那担忧简直溢出屏幕。毕竟谁也不想老了以后“忘东忘西”,连自己是谁都不记得。 这时候,就有人说了,年轻人提前吃含类黄酮的食物,能预防老年痴呆。这是真...
多吃含类黄酮食物真能预防老年痴呆?老年痴呆,也就是阿尔茨海默病,已经成为老年人健康的一大“杀手”,患病人数越来越多,不少家庭都因此陷入痛苦之中。 就在大家为预防老年痴呆愁得“头秃”的时候,有研究表明,多吃含类黄酮的食物可能有助于预防老年痴呆,这波研究成果属实是给大家带来了希望。那类黄酮是何方神...

医生警告:预防老年痴呆,常吃这三种食物,但许多老年人却置若罔闻!长期食用深海鱼类的老年人,通常在大脑健康和心血管方面都具有显著的优势。 小米 当人们谈论到改善脑部健康的食物时,往往会想到各种价格... 延缓老年痴呆的到来。 以上内容仅供参考,若身体不适,请及时咨询专业医生 关于可以预防老年痴呆的食物您有什么看法?欢迎评论区一起讨论...

身边的“天然叶酸”!隔三岔五吃一回,预防中风、老年痴呆很受益这也是它与预防老年痴呆相关的关键所在。值得一提的是,天然叶酸广泛存在于绿色蔬菜、豆类以及部分水果中,尤其是深绿色叶菜,几乎是“叶... 从预防角度看,适量补充叶酸并不是一蹴而就的事,而是需要长期坚持。像“隔三岔五吃一回”这样的频率,就足以让叶酸水平保持在较理想的状...

想给大脑减负预防老年痴呆?别只盯着核桃,这几样食物才是王炸!你以为多吃核桃就能给大脑减负,预防老年痴呆?大漏特漏!其实老年痴呆很可能和缺锌有关,核桃里锌含量一般般,下面这几样食物才是给大脑减负的王炸,赶紧码住! 生蚝:生蚝可是“海里的牛奶”,锌含量那叫一个高。锌是维持大脑正常功能的重要微量元素,就像给大脑这台精密仪器加的优...

血液黏稠,血管堵塞?常吃这样东西,溶解血栓,预防老年痴呆相信很多人也都了解吃豆豉的好处,有营养学研究结论表示,在日常生活中适当食用豆类食品,坚持一段时间能够很好地降低体内脂肪水平,有利于... 最为关键的是豆豉有助于预防血栓,稀释血液。2.是血栓患者可吃的“溶栓豆”对于中老年人来说,可能会因为脑血栓而诱发老年痴呆症,对于这...

预防老年痴呆!营养师推荐4道“黄金菜”,常吃头脑更灵活随着年龄的增长,保持大脑健康变得越来越重要,尤其是预防老年痴呆症。许多研究表明,合理的饮食可以对大脑功能产生积极的影响。营养学家推荐的几道“黄金菜”不仅营养丰富,而且对脑部健康有着显著的帮助。通过摄取富含植物卵磷脂、动物卵磷脂、锌、叶酸等重要营养素的食物...

预防老年痴呆!营养师推荐8道“黄金菜”,常吃头脑更灵活使山药泥更加细腻。 4. 将山药泥放入盘中,整理成喜欢的形状,淋上蓝莓酱,剩余的蓝莓可摆在上面作为装饰。 这 8 道“黄金菜”不仅美味可口,而且富含多种对大脑有益的营养成分,经常食用有助于预防老年痴呆,让我们的头脑更加灵活。为了家人和自己的健康,不妨在日常饮食中多安排这...
医生提醒老人:预防老年痴呆,这5类食物要少吃,或加速衰老但吃得太多,对大脑可不是什么好事。长期高糖饮食会导致胰岛素抵抗,影响大脑对葡萄糖的利用,进而损害神经细胞功能。研究发现,血糖水平过高会增加阿尔茨海默病的风险,甚至有人把它称为“糖尿病型脑病”。 为什么糖会伤害大脑? 促进炎症:糖分摄入过多,会引发慢性炎症,影响大脑...
>▽< 
飞飞加速器部分文章、数据、图片来自互联网,一切版权均归源网站或源作者所有。
如果侵犯了你的权益请来信告知删除。邮箱:xxxxxxx@qq.com
上一篇:吃什么药能预防老年痴呆症呢
下一篇:吃什么药能预防老年痴呆症





